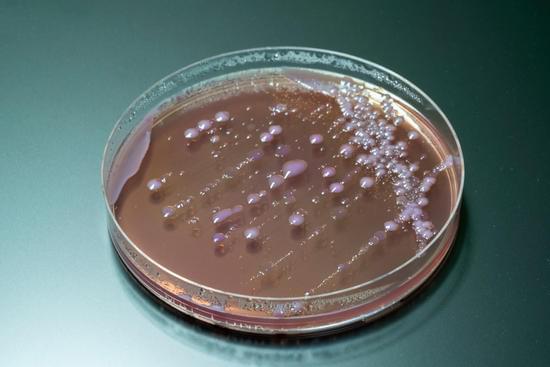
세균성 장염의 원인과 치료

세균성 장염의 원인과 치료
세균성 장염은 대장과 소장에 세균이 감염되어 발생하는 염증 질환입니다.
감염은 주로 오염된 음식이나 물을 통해 전파되며, 살모넬라, 대장균, 캠필로박터와 같은 다양한 병원성 세균이 원인이 됩니다.
이는 식중독의 주요 원인 중 하나로, 증상은 매우 급작스럽게 나타날 수 있습니다.
원인 및 감염 경로
1. 오염된 음식과 물:
충분히 익히지 않은 육류, 오염된 물, 날달걀, 비위생적인 조리 과정 등이 주요 원인입니다.
여행 중 현지의 비위생적인 음식이나 물을 섭취할 경우 발생하기 쉽습니다.
2. 감염원:
살모넬라(Salmonella): 주로 가금류, 계란, 유제품에서 발견됩니다. 식중독의 대표적인 원인 중 하나입니다.
대장균(Escherichia coli): 여러 종류가 있으며, 일부는 심각한 복통과 혈변을 유발합니다. 오염된 고기나 채소를 통해 전파됩니다.
캠필로박터(Campylobacter): 날고기나 덜 익힌 가금류, 오염된 물에서 발견됩니다. 설사와 복통을 주로 유발합니다.
증상
1. 초기 증상:
복통, 설사, 메스꺼움, 구토, 발열 등이 주로 나타납니다. 증상은 감염 후 몇 시간에서 며칠 이내에 시작되며, 심한 경우 혈변이 나타날 수 있습니다.
2. 심각한 증상:
탈수는 가장 큰 합병증 중 하나입니다. 특히 어린이, 노약자, 면역력이 약한 사람에게서 심각할 수 있습니다. 이 경우 입원 치료가 필요할 수 있습니다.
진단
세균성 장염은 주로 증상과 병력에 기반해 진단됩니다. 경우에 따라, 대변 검사를 통해 특정 세균을 확인할 수 있습니다.
이 검사로 어떤 항생제가 필요한지 결정하는 데도 도움이 됩니다.
치료 방법
1. 수분 보충:
설사와 구토로 인해 손실된 수분을 보충하는 것이 가장 중요합니다. 경구 수액이나 전해질 음료가 추천됩니다.
2. 항생제:
특정 세균에 의한 감염, 특히 심한 경우 항생제가 필요할 수 있습니다. 그러나 모든 세균성 장염에서 항생제를 사용하는 것은 아니며, 일부 경우에는 항생제가 오히려 병을 악화시킬 수 있습니다.
3. 식이 요법:
질병이 지속되는 동안에는 부드럽고 소화가 쉬운 음식을 섭취하는 것이 좋습니다. 기름진 음식, 고섬유질 음식, 유제품은 피하는 것이 권장됩니다.
예방
1. 음식의 철저한 조리:
고기, 특히 가금류와 계란은 충분히 익혀서 섭취해야 합니다. 음식 조리 시 손 씻기와 교차 오염 방지를 철저히 해야 합니다.
2. 안전한 물 사용:
여행 중에는 병에 든 물이나 끓인 물을 사용하고, 의심스러운 식품은 피하는 것이 좋습니다.
3. 위생 관리:
손 씻기, 식기 세척 등의 기본적인 위생 관리를 철저히 하여 감염을 예방할 수 있습니다.
자주 묻는 질문 (FAQ)
Q1: 세균성 장염과 바이러스성 장염의 차이는 무엇인가요?
A1: 세균성 장염은 세균에 의해 발생하며, 증상으로는 복통, 설사, 혈변 등이 있으며 항생제가 필요할 수 있습니다. 반면 바이러스성 장염은 노로바이러스, 로타바이러스 등에 의해 발생하며, 주로 자가 치유되며 수분 보충이 중요합니다.
Q2: 세균성 장염에서 피해야 할 음식은 무엇인가요?
A2: 기름진 음식, 고섬유질 음식, 유제품은 장염 증상을 악화시킬 수 있으므로 피해야 합니다. 부드럽고 소화가 쉬운 음식을 선택하는 것이 좋습니다.
Q3: 세균성 장염은 얼마나 빨리 회복되나요?
A3: 경미한 경우 3-7일 내에 회복될 수 있지만, 중증일 경우 몇 주간 지속될 수 있습니다. 적절한 치료와 수분 보충이 회복 속도에 중요한 영향을 미칩니다.
Q4: 세균성 장염이 전염될 수 있나요?
A4: 네, 세균성 장염은 전염될 수 있으며, 특히 손 위생이 부족하거나 오염된 음식, 물을 통해 쉽게 퍼질 수 있습니다. 철저한 위생 관리가 중요합니다.
허혈성 대장염에 대한 이해
허혈성 대장염에 대한 이해허혈성 대장염이란?허혈성 대장염은 대장에 혈액 공급이 부족해지는 질환으로, 이는 대장 벽의 염증과 괴사를 유발할 수 있습니다.혈액 공급이 제한되면 조직이 산소
namo38.com
'의학에 대해서' 카테고리의 다른 글
| 하지정맥류 약물 치료 (0) | 2024.08.24 |
|---|---|
| 피부 홍조의 원인과 치료 (0) | 2024.08.23 |
| 부비동암과 비강암: 상세한 개요와 차이점 (0) | 2024.08.23 |
| 어깨 통증을 치료하기 위해 사용되는 주사 치료제 (0) | 2024.08.22 |
| 부비동염의 원인과 치료 및 관리 방법 (0) | 2024.08.22 |
댓글